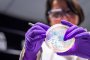
Учени подмладиха човешки клетки

Вторият модел от „Neue Klasse“ на BMW е напълно електрическа версия на емблематичната Серия 3, като се очаква и вариант с бензинов двигател. (ВИЖ ФОТОГАЛЕРИЯ ТУК) Показаха един от най-важните автомобили на BMW за 21-ви век. Серия 3 е определящият...

Излезе нова бета версия на ...

Така наречената контейнерна ...

Обикновен кръвен тест може да ...

За да отговори на нуждите на ...

Коронавирусната епидемия засегна ...

Коронавирусната епидемия засегна ...
Група учени от университета в ...





Доналд Тръмп обяви, че вторник, 7 април ще ...

бТВ Екшън 22 февруари 21:00ч.
Режисьор: Бър Стиърс (Burr Steers)
В ролите: Зак Ефрон Майк О'Донъл Матю Пери (Майк О'Донъл) Матю Пери Майк О'Донъл Лесли Ман (Скарлет) Лесли Ман Скарлет Томас Ленън (Нед) Томас Ленън
Във Фейсбук:
- Здравейте група! Пия билката шафран, но не знам за какво помага
Коментар:
- И аз пия ракия - без да знам за какво помага...от 36 години, най-редовно без да пропускам вечер...
1-ва английска гимназия рекламира Радев предизборно
Преди 2 месеца Румен Радев обяви отказа ...